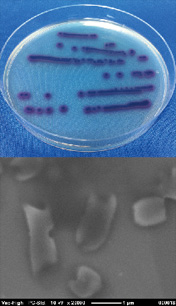
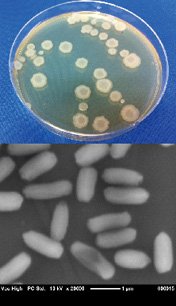
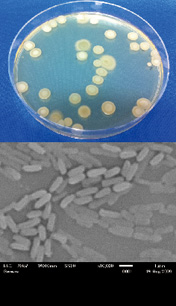
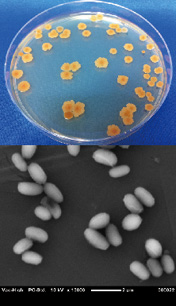
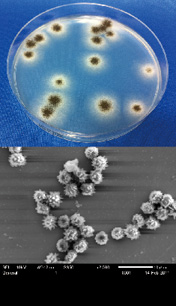

技術資料
紫外線殺菌における指標微生物の紫外線感受性(その3)
技術本部 研究開発部 光応用研究課
キーワード
紫外線,殺菌,指標微生物,指標菌,紫外線感受性
殺菌・滅菌(紫外線殺菌・電子線滅菌)のご案内
紫外線を放射する殺菌ランプを利用した紫外線殺菌ソリューション「殺菌・滅菌(紫外線殺菌・電子線滅菌)」の詳細は以下よりご覧いただけます。
- 殺菌・滅菌(紫外線殺菌・電子線滅菌)
3.指標微生物の紫外線感受性
3.1 細菌(Bacteria)-大腸菌,黄色ブドウ球菌
大腸菌や大腸菌群などの細菌は,上水(飲料水)や下水などの水質基準の分析項目として挙げられているため,紫外線殺菌装置の性能を見る指標菌として使用されるケースがある。大腸菌(Escherichia coli)は,グラム陰性の桿菌で,乳糖(ラクトース)を分解して酸とガスを産生する好気性または通性嫌気性の細菌で,腸内細菌であることから糞便汚染の指標として用いられる。上水(水道法)の水質基準では,「大腸菌は検出してはならない」とされている4)。また大腸菌群(Escherichia coli group)は,試料が糞便によって汚染されている疑いを示す公衆衛生的な指標として実用面から定義されたもので,大腸菌以外の大腸菌亜種と呼ばれる,Citrobacter属,Enterobacter属,Klebsiella属等が含まれ,一般には,グラム陰性,無胞子の短桿菌で,乳糖を分解してガスと酸を生成する好気性あるいは通性嫌気性菌の総称である5)。下水(下水道法)では大腸菌群を指標として放流水中に3000個/mℓ以下との定めがある。近年,下水の消毒においても,放流先の河川等の自然環境への配慮から塩素消毒に代り,紫外線による消毒装置が普及してきている。
図2に大腸菌のEZ2C寒天培地上で培養した状況および電子顕微鏡(SEM)像を示す。EZ2C寒天培地には発色基質(色素)が含まれ,大腸菌が増殖した場合,その色素を吸収して増殖し赤紫色に変色するため目視で選別できる(実際の大腸菌は赤色を帯びてはいない)。また,SEM像には大腸菌の細胞の一部が削られた像が得られている。SEMサンプルを作製する段階で乾燥状態になるため大腸菌の細胞が破壊したものと思われる。図3に大腸菌(E. coli)NBRC 3972の紫外線による感受性試験の結果(生残曲線)を示す。図のX軸は紫外線照射量(mJ/cm²),Y軸は対数生残率(log(Ct)/(Co))を表す。大腸菌の生残曲線は初期に大きな肩部のある曲線となりDs値(肩部の紫外線照射量)=5.2,D値(90%殺菌に要する紫外線量)=1.5,3 log値(3桁下げるのに要する紫外線照射量)=9.8(mJ/cm²)と計算された。グラム陰性菌の場合は,比較的紫外線感受性が高い(紫外線耐性が低い)菌が多く見られる。
図2 大腸菌(Escherichia coli)集落(EZ2C培地)とSEM像(20000倍)

図3 大腸菌(Escherichia coli)NBRC 3972
腸内細菌ではなく環境菌を対象としたい場合,黄色ブドウ球菌(Staphylococcus aureus)がよく使用される。黄色ブドウ球菌は,通性嫌気性のグラム陽性の連鎖球菌で,人の皮膚表面,毛孔や鼻腔内に存在する常在細菌であり,免疫力が低下すると感染する日和見感染菌でもある。薬剤耐性を獲得したMRSA(メチシリン耐性黄色ブドウ球菌)は院内感染で重篤な病状になるとして問題とされる菌である。図4に黄色ブドウ球菌のマンニット培地上の集落とSEM像を示す。自然環境下に置くと黄色を呈した球形の菌が観察される。図5に黄色ブドウ球菌(S. aureus)の生残曲線を示す。黄色ブドウ球菌の生残曲線も初期に肩部が見られ,Ds値=2.6,D値=1.5,3 log値=9.4(mJ/cm²)と計算される。黄色ブドウ球菌の紫外線感受性は大腸菌と同等レベルであった。なお,使用した大腸菌(E. coli NBRC 3972)および黄色ブドウ球菌(S. aureus NBRC 13276)は,日本工業規格の抗菌性試験方法(JIS-Z 2801:2006),ならびに日本薬局方の微生物限度試験法に掲載される菌株を使用した。

図4 Staphylococcus aureus 集落(マンニット培地)とSEM像(10000倍)

図5 黄色ブドウ球菌(Staphylococcus aureus) NBRC 12732
3.2 芽胞形成菌
和名で枯草菌と呼ばれるBacillus subtilisはグラム陽性の桿菌で,環境条件が悪化すると耐久性の高い芽胞(spore)を形成する。芽胞形成菌の特長は,熱,乾燥,消毒薬に極めて強い抵抗性があり乾燥環境表面で長期間生存することができるため,医療機器として使用される滅菌器の指標菌として用いられている。現在,最終滅菌法で掲載される芽胞形成菌は,高圧蒸気滅菌器(オートクレーブ)やホルムアルデヒド消毒器に対しては,Geobacillus stearothermophilus spore,EOG(エチレンオキサイド)滅菌器および乾熱滅菌器では,Bacillus atrophaeus spore,γ線や電子線などの放射線滅菌についてはBacillus pumilus sporeが指標とし用いられている6),7)。滅菌の指標菌として芽胞形成菌が使用される最大の理由は,その芽胞(spore)が,極めて殺滅しにくい構造を有していることによる。紫外線殺菌法は,冒頭にも述べたように滅菌器として使用されていないため指標菌の定めは無いが,典型的な芽胞形成菌である枯草菌(Bacillus subtilis)が旧来より頻繁に使用されている。ただし,紫外線耐性のある菌であることを検証して使用している訳ではない。
図6~9に寒天培地上で培養した芽胞形成菌の集落(colony)の状況および電子顕微鏡(SEM)像を示す。培養後の集落は同じ芽胞形成菌でも,それぞれ形状や色調が異なり,集落を観察することでも菌の違いが判別できる。SEM像については,みな大豆のような形状をしているが,長さについては違いが見られる。図10にBacillus subtilis(ATCC 35021)sporeの紫外線による生残曲線を示す。生残曲線は,初期の肩部はあまり見られずDs値=1.0,D値=6.3,3 log値=19.8(mJ/cm²)となった。図11にBacillus pumilus(ATCC 27142)sporeの紫外線による生残曲線を示す。生残曲線は,初期に肩部が見られDs値=7.6,D値=8.1,3 log値は31.8(mJ/cm²)となった。図12にBacillus atrophaeus(ATCC 9372)sporeとの紫外線による感受性試験結果を示す。生残曲線は,Ds値=5.8,D値=6.6,3 log値=25.7(mJ/cm²)と計算された。図13にGeobacillus. stearothermophilus(ATCC 12980)sporeの紫外線による感受性試験結果を示す。生残曲線より初期に肩部が見られDs値=5.1,D値=6.3,3 log値=24.0(mJ/cm²)と計算された。同じ芽胞形成菌であっても紫外線感受性は,それぞれ異なることが分かった。調べた4種の芽胞形成菌の中ではγ線や電子線などの放射線滅菌の指標とされているBacillus pumilus sporeが紫外線抵抗性の高い傾向が見られたが,菌株によっても感受性は異なるため,紫外線に一番耐性ある芽胞形成菌として断定することはできない。
図6 枯草菌(B. subtilis)集落(SCD培地)とSEM像(20000倍)

図10 Bacillus subtilis(ATCC 35021)spore
図7 Bachillus pumilus集落(SCD培地)とSEM像(10000倍)

図11 Bacillus pumilus(ATCC 27142)spore
図8 Bacillus atrophaeus集落(SCD培地)とSEM像(10000倍)

図12 Bacillus atrophaeus(ATCC 9372)spore

図9 Geobacillus stearothermophylus集落(SCD培地)とSEM像(10000倍)

図13 Geobacillus. stearothermophilus(ATCC 12980)spore
3.3 真菌(Fungi)-黒かび
食品や食品容器の製造工程では,食品に付着した黴(かび)の混入が商品の消費期限を低下させる原因となることから,黴を対象とした殺菌を行うことも多い。黴の中では紫外線耐性の強い黴として知られる黒かび(Aspergillus niger)胞子は紫外線殺菌の指標微生物として頻繁に利用される。黴は真菌(真核微生物)であり,細菌(原核微生物)と比べ細胞は大きく,細胞分化は遥かに高度である。図14に黒かび(Aspergillus niger)のPDA培地上の生育状況,および胞子のSEM像を示す。黴胞子は,適環境では菌糸を伸ばし生長し,生殖細胞である多数の胞子(spore)を形成する8)。その胞子を集めて紫外線の不活化評価に用いる。
図15にAspergillus niger NBRC 105649胞子,図16にAspergillus niger NBRC 9455胞子の紫外線照射による生残曲線を示す。2種の菌株は,同じ黒かび(A.niger)であるが,日本工業規格かび抵抗性試験方法(JIS Z 2911:2010)に記載されたNBRC 105649,ならびに日本薬局方の培地性能試験に記載されたNBRC 9455の菌株を採用した。生残曲線は,双方とも肩の少ない直線状のラインとなったが,紫外線の感受性には明らかな相違が見られた。NBRC 105649はD値=87.0,3 log値=260.9(mJ/cm²)となったのに対しNBRC 9455はD値=138.9,3 log値=416.7(mJ/cm²)となり,NBRC 9455のほうが,紫外線耐性の強い黒かび菌株であることが分かった。このことは,同じ微生物種であっても,紫外線感受性は異なる場合があることを示しており,同じ菌種であるからといって同程度の紫外線感受性であると判断するのは危険である。
図14 Aspergillus niger生育状況(PDA培地)とSEM像(2500倍)

図15 黒かび(Aspergillus niger)NBRC105649

図16 黒かび(Aspergillus niger)NBRC 9455
3.4 原虫,ウイルス(Virus)
紫外線は,原虫やウイルスにも有効であることが知られているため,塩素消毒を補完するかたちで感染予防,消毒のため利用されるケースがある。上水道においては原虫(クリプトスポリジウム等)対策の強化のため,紫外線処理設備の導入が進められている9),10)。不活化に必要な原虫の紫外線照射はジアルジア(Giardia)99%(2 log)不活化で5mJ/cm²,クリプトスポリジウム(Cryptosporidium)99.9%(3log)不活化で10(mJ/cm²)としている。紫外線の測定方法は異なるかもしれないが,原虫に対しては大腸菌などの細菌類と同等の紫外線照射量で不活化が可能と考えられる。

図17 Escherichia coli Phage MS2 NBRC 102619
紫外線処理設備の紫外線消毒のガイドラインによれば「紫外線処理設備の指標微生物としては,病原性がなく安全で第三者機関が追試可能な微生物の中から選択する。」とされ,代表的な事例としては,枯草菌(Bacillus subtilis),大腸菌(E. coli),あるいはQβ,MS2等のファージが挙げられている。ここで出てくるファージとは,大腸菌を宿主(Host細菌)とするウイルス(Virus)で,大腸菌ファージ(E. coli Phage),または単にファージ(Phage)と呼ばれる。図17に大腸菌ファージE. coli Phage MS2(NBRC 102619)の紫外線感受性試験結果を示す。生残曲線は細菌とは異なり,初期に肩部が見られない直線性を示し相関性も高いラインとなった。この生残曲線より,D値=20.2,3 log値=60.6(mJ/cm²)と計算される。芽胞形成菌と比較すれば紫外線感受性の低い(紫外線耐性のある)微生物といえる。
参考文献
- 上水試験法より,解説編,V 微生物試験,第3章 糞便性指標,2001年版.
- 下水試験方法より,上巻,第3章,衛生学試験,p.698,1997年版.
- 佐々木次雄,中村晃忠,三瀬勝利:滅菌法及び微生物殺滅法,財団法人 日本規格協会,pp.63-70(1998).
- 佐々木次雄,他:ヘルスケア製品の滅菌および滅菌保証,9章 バイオロジカルインジケータ pp.355-356 (2011).
- 渡辺一仁,土戸哲明,坂上吉一:微生物胞子,第6章 カビ・酵母胞子の基礎,p.136,サイエンスフォーラム (2011).
- 木暮昭彦:e-Water の成果~紫外線消毒ガイドライン~,第9回日本水環境学会シンポジウム講演集 (2006).
- 平成19年3月30日付 厚生労働省健康局水道課事務連絡「紫外線処理設備について」.
テクニカルレポートに掲載されている内容は、原稿執筆時点の情報です。ご覧の時点では内容変更や取扱い中止などが行われている可能性があるため、あらかじめご了承ください。
